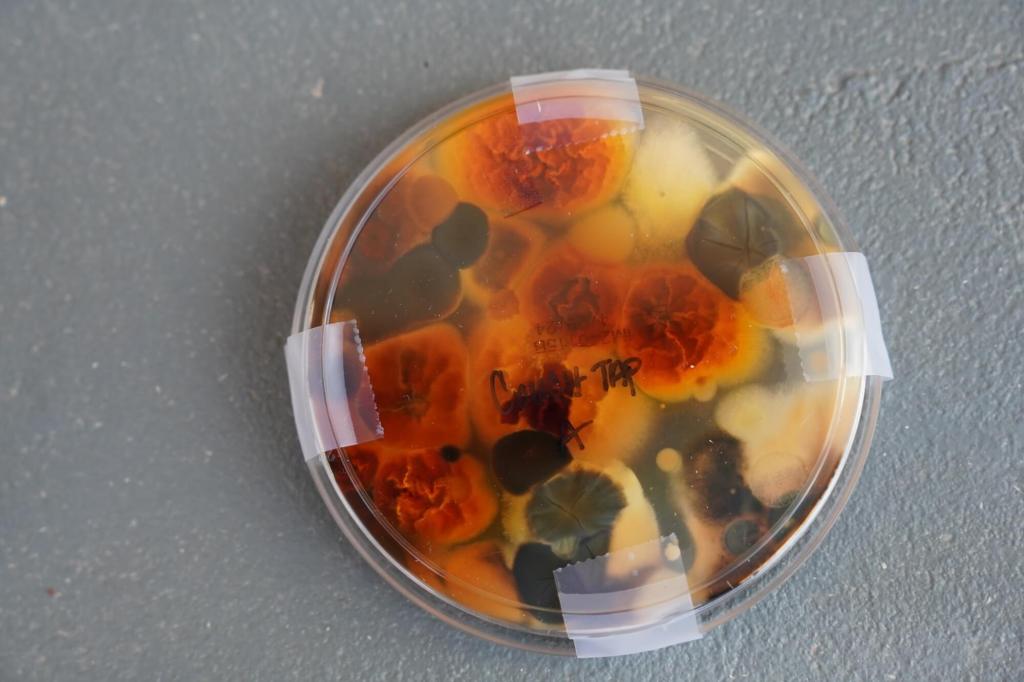

My goal is to help you achieve Cleaner, Healthier air. Especially since the 1970’s Energy Crisis resulted in “tighter homes”, the EPA has found that levels of indoor air pollutants are often two to five times higher INDOORS as compared to outdoors; in some cases – 100 times higher. And studies have found 50% or more of homes have problem levels of mold. Allergic reactions to Pet Dander, Pollen, VOC’s and other types of IAQ (Indoor Air Quality) problems are also common. … and most people spent over 90% of their time indoors.
Before becoming certified as an Indoor Air Quality focused Mold Assessor, plus other certifications, I learned the hard way how serious and all-to-common these issues can be. SEE “ABOUT” tab.
Call us today to learn how we can help you evaluate and improve your Air Quality.
Mold & Moisture Assesment and Testing
Our professional Assessment (inspection) and testing of your home or office will help you determine if improvements are needed.
This includes a report of findings, including sample results. We will review the report with you and answer your questions.
SEE “SERVICES” tab.
: HOMEAir Cleanse & Sanitize
We offer a variety of more natural methods to address and improve air quality issues.
We can help “Pretty good air quality” become substantially cleaner. This includes recommended long-term solutions that really work.
We can also provide other HELP!
